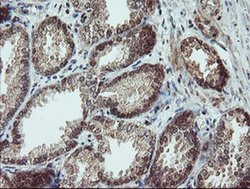
Invitrogen SENP2 Monoclonal Antibody (OTI3E7) 100 &mu;L; Unconjugated:Antibodies,
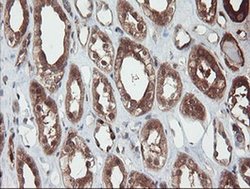
Invitrogen SENP2 Monoclonal Antibody (OTI3E7) 100 &mu;L; Unconjugated:Antibodies,

missing translation for 'onlineSavingsMsg'
Learn More
Learn More
Invitrogen™ SENP2 Monoclonal Antibody (OTI3E7)


Mouse Monoclonal Antibody
Brand: Invitrogen™ MA526377
This item is not returnable.
View return policy
Description
SENP2 Monoclonal Antibody for Western Blot, ICC/IF, IHC (P), Flow
SUMO is a small ubiquitin-like protein that can be covalently conjugated to other proteins. SENP2 is one of a group of enzymes that process newly synthesized SUMO1, SUMO2, and SUMO3 into the conjugatable mature forms and catalyze the deconjugation of these same SUMO proteins from their targeted substrates. SENP2 may also down-regulate CTNNB1 levels and thereby modulate the Wnt pathway.
Specifications
| SENP2 | |
| Monoclonal | |
| 1 mg/mL | |
| PBS with 1% BSA, 50% glycerol and 0.02% sodium azide; pH 7.3 | |
| Q9HC62 | |
| SENP2 | |
| Human recombinant protein fragment corresponding to amino acids 139-523 of SENP2 produced in E.coli. | |
| 100 μL | |
| Primary | |
| Human, Monkey | |
| Antibody | |
| IgG1 |
| Flow Cytometry, Immunohistochemistry (Paraffin), Western Blot, Immunocytochemistry | |
| OTI3E7 | |
| Unconjugated | |
| SENP2 | |
| 2310007L05Rik; 4930538C18Rik; AI646780; AW554757; Axam; Axam2; Axin-associating molecule; CT; EGK_11819; KIAA1331; mKIAA1331; Senp2; sentrin/SUMO-specific protease SENP2; Sentrin-specific protease 2; Smt3ip2; SMT3-specific isopeptidase 2; SUMO specific peptidase 2; SUMO/sentrin specific peptidase 2; SUMO/sentrin specific protease 2; SUMO-1 protease 1; SUMO-1 protease-1; SUMO1/sentrin/SMT3 specific peptidase 2; SUMO1/sentrin/SMT3 specific protease 2; SUMO-1/Smt3-specific isopeptidase 2; Supr1; SuPr-1 | |
| Mouse | |
| Affinity Chromatography | |
| RUO | |
| 59343 | |
| -20°C, Avoid Freeze/Thaw Cycles | |
| Liquid |
Product Content Correction
Your input is important to us. Please complete this form to provide feedback related to the content on this product.
Product Title
Spot an opportunity for improvement?Share a Content Correction